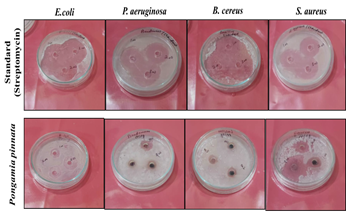

Research Article
Eco-Friendly Fabrication of Silver Nanoparticles from Pongamia Pinnata: A Novel Therapeutic Antibacterial Agent
Reproductive Biomedicine & Natural Products Lab, Department of Zoology, University of Rajasthan, Jaipur, India.
*Corresponding Author: Prity Yadav, Reproductive Biomedicine & Natural Products Lab, Department of Zoology, University of Rajasthan, Jaipur, India.
Citation: Yadav P., Bharti N., Ashish K. Kansotiya, Pratap C. Mali (2025). Eco-Friendly Fabrication of Silver Nanoparticles from Pongamia pinnata: A Novel Therapeutic Antibacterial Agent, Clinical Case Reports and Studies, BioRes Scientia Publishers. 10(5):1-11. DOI: 10.59657/2837-2565.brs.25.269
Copyright: © 2025 Pratap Chand Mali, this is an open-access article distributed under the terms of the Creative Commons Attribution License, which permits unrestricted use, distribution, and reproduction in any medium, provided the original author and source are credited.
Received: July 05, 2025 | Accepted: July 19, 2025 | Published: July 26, 2025
Abstract
The emergence of multidrug-resistant bacteria necessitates the exploration of novel and eco-friendly antimicrobial agents. The present study explores the antibacterial potential of silver nanoparticles (AgNPs) synthesized using Pongamia pinnata leaf extract, a sustainable and eco-friendly method rooted in green nanotechnology. The biosynthesized AgNPs were characterized by their distinct colour change and confirmed via UV-VIS spectroscopy, indicating nanoparticle formation. Dynamic light scattering revealed a uniform size distribution of the biosynthesized AgNPs, Zeta potential analysis confirmed their colloidal stability, and SEM imaging demonstrated spherical morphology with nanoscale dimensions. The antibacterial activity was evaluated against a range of Gram-positive and Gram-negative bacterial strains, including Staphylococcus aureus, Escherichia coli, Bacillus cereus, and Pseudomonas aeruginosa, through agar well diffusion. Results demonstrated significant antibacterial efficacy, with enhanced zone inhibition compared to conventional treatments. The zones increased proportionally with the concentration of nanoparticles, indicating a dose-dependent antibacterial effect. The synergistic effect of phytochemicals in Pongamia pinnata and the inherent antimicrobial properties of silver contributed to the observed results. This study highlights the potential of Pongamia pinnata-mediated AgNPs as a promising candidate for developing plant-based antibacterial agents, offering a novel approach in the field of phytomedicine and nanobiotechnology.
Keywords: pongamia pinnata; antibacterial, AgNPs; gram positive; gram negative; zone inhibition
Introduction
Since manipulation of materials and miracles at the nanoscale, where material properties react very differently from bulk material, is the focus of nanoscience [1]. From the beginning of civilization, nanotechnology has been used to create unique items. Ancient Romans employed various quantities of gold and silver to tint glass in hues of mauve and yellow [2]. In the ninth century, researchers examined how metal oxides reduced when heated to high temperatures, producing nanoparticles [3]. By adding carbon disulfide to a chloroauric acid solution and reducing it, Michael Faraday produced the first known chemical synthesis of metal nanoparticles in 1857. The result was a dark-red gold liquid [4]. A recent interdisciplinary field called nanoscience is dependent on the fundamental characteristics of nanoscale things [5]. The engineering of nanomaterials made possible by nanotechnology is one of the most in-demand fields of study in both academia and business. Owing to their small size and high surface-to-volume ratios, nanoparticles have found uses in pharmaceutics, photonics, drug delivery systems, and other fields where they are not present in bulk materials [6-7]. Usually possessing unique physical, chemical, and biological characteristics, these materials are remarkable due to their uncommon size [8]. Nanoparticles are sub-microscopic particles having a minimum size (1D) of less than 100 nm. Noble metal nanoparticles, such as silver, gold, and platinum, were created by synthesis and have been widely used in research on antibacterial and antifungal agents [9]. The multitude of uses for metallic nanoparticles has led to a surge in the investigation of the most effective methods for their preparation [10]. Certain components of active plant extracts serve as reducing agents in addition to being essential to the synthesis of AgNPs and helping to stabilize and cap nanoparticles [11]. In biological and medicinal sciences, silver nanoparticles are used as focused medication delivery methods. Silver nanoparticles, a type of metal nanoparticle, are particularly well-known for their potent antibacterial and anti-inflammatory properties. Many physical, biological, and pharmacological disciplines use AgNPs. For example, Burns and wounds are treated with AgNPs to prevent bacterial infection [12]. Plant extracts are thought to be a great source for the environmentally friendly synthesis of AgNPs, which have a variety of therapeutic uses. AgNPs are one of the pharmaceutically promising nanoparticles [13]. If plants or plant extracts could be used to create nanoparticles extracellularly in a regulated manner based on their size, shape, and dispersity, then biosynthetic procedures for nanoparticles would be more beneficial. Utilizing plants to synthesize nanoparticles could have advantages over other biological processes that are safe for the environment because it does not require the laborious process of sustaining cell culture [14]. The amount and structure of AgNPs will differ depending on the plant type since plants include various metabolites that can stabilize and cap AgNPs and diminish silver ions [15]. Resveratrol, curcumin, ginsenosides, triptolide, and other polyphenolic alkaloid chemicals with antioxidant properties are found in plants and are referred to as flavonoids [16]. In the current study, we describe the creation of bioactive Ag nanoparticles utilizing Pongamia pinnataleaf extract as the biomaterial.Although medications made from plants provide a new, bright future for research, antioxidants and secondary metabolites are a few naturally occurring bioactive substances found in plants. Therefore, using plant extract as an antibacterial agent is preferred [17].
A fairly common plant in India is Pongamia pinnata, which belongs to the Fabaceae family. Pongamia pinnata is referred to as Indian beech in English, kanuga in Telugu, and Karanja in Hindi. From a botanical standpoint, the nomenclature of genera can be particularly complex because multiple species from various genera might be used interchangeably [18]. Seeds of the plant have been used to produce pinnatin, pongapin, kanjone, pongagalabrone, and karangin. The stem and leaves of the plant include flavones and chalcone derivatives such as Pongagallone A and B, Galbone, Pongone, and Pongalbol. Pongamia pinnata fruits include three new pongamosides, A–C, which are furnoflavanoid and glucosides, and pongamoside D, a unique flavanol glucoside. The Pongamia pinnata root extract contains anticancer medications such as etoposide, paclitaxel, fluorophenylalanine, vinblastin, and vincristine (sulfate) [19]. In conventional medical systems, nearly every element of this plant is utilized as a blood purifier, antiseptic, and wound healer. The plant Pongamia pinnata is a medicinal plant that has been used in Ayurvedic and Unani medicine systems for its anti-inflammatory, antiplasmodial, antinociceptive, antihyperglycemic, anti-lipid peroxidative, antidiarrheal, antiulcer, antihyperammonaemic, antioxidant, and antibacterial properties [20]. A redox imbalance brought on by an excess of ROS (Reactive Oxygen Species) production leads to the production of several inflammatory compounds [21]. A significant amount of research has shown the worrying rise in multidrug-resistant bacteria, which highlights the evolution of antibiotic resistance among pathogens as a growing worldwide health risk [22]. In many regions of the world, Natural medicinal plant items have been utilized for many years as invaluable treatments for a wide range of illnesses since they are readily available and reasonably priced [23]. It has been observed by Khan and Mali (2017) that several medicinal plants have antibacterial action in addition to other pharmacological qualities [24]. Antibiotic usage has completely changed how many different bacterial infections are treated. However, the widespread use of these drugs has resulted in an alarming rise in antibiotic resistance in microbes; the discovery of novel antimicrobials is necessary [25]. Pongamia pinnata has numerous traditional uses that have inspired researchers to examine its pharmacological characteristics and confirm the uses of this species as a treatment [26]. The leaf chloroform fraction of Pongamia pinnata showed enhanced antibacterial activity against Pseudomonas aeruginosa, Staphylococcus aureus, and E. coli. When it came to inhibiting P. aeruginosa and E. coli, the acetone part worked better than normal. The petroleum ether fraction did not significantly inhibit microorganisms as compared to the reference [27].
Ag NPs are extremely reactive and efficient at preventing the growth of microbes due to their small size and large surface area. Numerous processes, including the release of silver ions, the breakdown of the bacterial cell membrane, and the inhibition of bacterial enzymes, are thought to be responsible for the antibacterial activity of Ag NPs. As a result, they have attracted a lot of interest recently as a potential source for new antiviral, antifungal, and antibacterial drugs [34]. The biological approach is a less costly, cleaner, nontoxic, biocompatible, and frequently one-step procedure that uses biomolecules like DNA, protein, and enzymes found in fungi, microbes, algae, and plants as well as secondary metabolites like phenolics, flavonoids, terpenes, and carbohydrates as reducing, capping, and stabilizing agents. To create uniformly sized nanoparticles that are selective and sensitive to biomolecular targets and have a broad range of biomedical applications, biomolecule-mediated synthesis (DNA, protein, and enzymes) provides a specific nucleation site during nanoparticle production [35]. The plant extract is a relatively spontaneous method among the several biological entities utilized for NPs synthesis because it doesn't need any particular procedures like isolation, culture, or culture maintenance. Furthermore, the synthesis of AgNPs mediated by plant extracts is typically faster than that of microorganisms, which is very cost-effective and relatively simpler for the bulk synthesis of NPs [36]. In this study, both gram-positive and gram-negative bacterial strains, i.e., S. aureus, B. cereus, and P. aeruginosa, E. coli, were chosen. One of the main human pathogens that causes a variety of clinical infections is Staphylococcus aureus. In addition to osteoarticular, skin and soft tissue, pleuropulmonary, and device-related infections, it is a major cause of bacteraemia and infectious endocarditis [45]. A major concern is the growth of multidrug-resistant strains of S. aureus, which show rapid development of antibiotic resistance [46]. B. cereus is a common bacterium that is found in many different places. Its ability to produce spores extends its survival in temperature extremes. Bacillus cereus is brought on by eating food infected with the emetic toxin or enterotoxigenic B. cereus. In non-gastrointestinal illnesses, B. cereus strains carrying the genes for the B. anthracis toxin have been linked to reports of respiratory infections resembling pulmonary anthrax [47]. In addition to being a component of commensal gut flora, E. coli can be found on hospital and long-term care floors. In this environment, E. Coli, the most prevalent gram-negative bacterium in the human gastrointestinal tract, is not virulent. A common cause of nosocomial infections, such as ventilator-associated pneumonia (VAP) and catheter-associated urinary tract infections (UTIs), is E. coli [48]. In the environment, Pseudomonas aeruginosa is frequently encountered, especially in freshwater. Urban communities often have swimming pools, jacuzzis, and hot tubs as reservoirs. It can result in a variety of community-acquired diseases, including otitis externa, pneumonia, folliculitis, and puncture wounds that can induce osteomyelitis. As a frequent opportunistic pathogen, it also plays a significant role in nosocomial infections, such as urinary tract infections linked to catheter use and ventilator-associated pneumonia [49].
Materials and Methods
Bacterial strains and reagents
All chemicals and media used were of the purest grade and purchased from Rankem, India. The test organisms used for the antibacterial assay were Escherichia coli (MTCC1652), Pseudomonas aeruginosa (MTCC741), Bacillus cereus (MTCC441), and Staphylococcus aureus (MTCC3160). All the strains were obtained from Bio Mitra Pvt. Ltd., Jaipur. All solutions were made using ultra-filtered high-purity deionized water. An evergreen plant called Pongamia pinnata was collected between July and August. Pongamia pinnata leaves were collected in enough quantity in and around the Department of Zoology, University of Rajasthan, Jaipur, and silver nitrate of Rankem India (CAS No. 7761-88-8) from the Zoology Department store procured under RUSA 2.0 Program project no. 5. Identification of the plant was done at Department of Botany, University of Rajasthan, Jaipur with herbarium number RUBL21227.
Preparation of Pongamia pinnata leaves extract
To get rid of dirt and debris, leaves of Pongamia pinnata were washed and shade dried, and after drying, converted to powdered form. 50 g of finely powdered leaves were carefully mixed in 1:1 of methanol and MilliQ water to boil for extract preparation. The first Whatman filter paper was used to filter the cooled extract. The filtrate was gathered and kept cold (4°C) until it was needed again (Figure 1).
Figure 1: Schematic representation of the preparation of Pongamia pinnata leaf extract. Fresh leaves of Pongamia pinnata were collected, washed, shade-dried, and ground into fine powder. The plant powder was then subjected to methanolic extraction by boiling in distilled water. The extract was filtered to remove solid residues, yielding a clear plant extract solution. This extract was subsequently used as a reducing and stabilizing agent for the green synthesis of silver nanoparticles.
Biosynthesis of silver nanoparticles
Visual observation: Using the green synthesis method, 100 mL of Pongamia pinnata leaf extract was gradually added to an aqueous AgNO3 solution heated to 60-80ºC for an hour to reduce the Ag+ ions and produce silver nanoparticles. The color changed from transparent to dark brown, indicating the presence of silver nanoparticles. To confirm the accuracy of the ocular observation method, ultraviolet-visible spectral analysis was conducted (Figure 2a & 2b).
Figure 2: (a & b) UV-Vis absorption spectrum and visual color change indicating the formation of silver nanoparticles (AgNPs) using Pongamia pinnata leaf extract. Figures a & b display the reaction mixture's color change from colorless (or pale yellow) to brown, signifying the reduction of Ag⁺ ions and formation of AgNPs. The color change correlates with the appearance of the SPR peak, typical of colloidal silver nanoparticles. (c) The UV-Vis spectrum shows a characteristic surface plasmon resonance (SPR) peak around 424nm, confirming the synthesis of AgNPs.
Characterization of silver nanoparticles
For analysis of the UV-VIS spectrum sample was prepared, and an experiment was conducted for plant extract solution treated with AgNO3 by varying concentrations of AgNO3 and plant extract. UV-VIS spectroscopy confirms the formation of AgNPs and is scanned in the range of 300-700 nm [28] by using a Thermo Scientific multiscan Go spectrophotometer in Department of Zoology, University of Rajasthan. Surface charges and size distribution of nanoparticles floating in a liquid are quantified using DLS. DLS was utilized to evaluate the hydrodynamic particle size distribution, polydispersity index (PDI), and surface charge of the biosynthesized AgNPs [37]. The colloidal stability of nanoparticles is influenced by their surface charges, which are revealed by zeta potential studies [38]. Zetasizer, Nano ZS (Malvern Instruments, UK) was used to measure the size of the nanoparticles using a nominal 5 mW He-Ne laser operating at a 633 nm wavelength at MNIT MRC, Jaipur. SEM is widely used to characterize nanoparticles by providing high-resolution images of their surface morphology and size. It helps in assessing particle shape, distribution, and aggregation, offering crucial insights into their structural properties [29]. The Nova NanoSEM450 was used for SEM at 15.00 kv in high vacuum mode with a 400 nm line resolution at MRC MNIT, Jaipur.
Assessment of Antibacterial potential of silver nanoparticles
The Agar well diffusion method was used to assess the antibacterial activity of the particle against both gram-positive and gram-negative bacteria. To inhibit bacterial growth, different concentrations of the AgNPs in samples were evaluated, along with leaf extract and pure water as negative controls. The area of inhibition surrounding the wells served as a visual representation of the antibacterial properties of AgNPs [1]. Standard microbial technique, the Agar Well Diffusion method [30], was used for in-vitro antibacterial assay. Gram-positive bacterial strains S. aureus and B. cereus, as well as gram-negative bacterial strains E. coli and P. aeruginosa, were evaluated to determine the antibacterial efficacy of AgNPs made from Pongamia pinnata.
Three distinct concentrations (100 mg/L, 200 mg/L, and 300 mg/L) of each drug were created after the various samples were diluted using 10% dimethyl sulphoxide. Disinfected Petri dishes holding the nutrient agar medium were used for the inoculation of test microorganisms. The inoculum was spread all over the dish using a spreader and allowed to stand for 30 min. Wells of 6 mm diameter were prepared in the seeded agar plates. In a different Petri plate, the standard drug was also loaded at similar concentrations. All different concentrations of all the samples and standard drug (30μl) were poured into the pre-organized wells of seeded plates. The plates were kept for incubation at 37ºC for 24 hrs. By measuring the inhibition zone surrounding each prepared well, the antibacterial spectrum of the test sample was ascertained. The sizes of the inhibition zones produced by the test sample and the commercially available antibiotics (streptomycin) were compared.
Statistical analysis
Each experiment is repeated twice. Mean and standard deviation (SD) are used to represent the results in this study. A one-way ANOVA test was used to determine if there were any statistically significant differences between the tested microorganisms. Data analysis was carried out using GraphPad PRISM 8.3 software (GraphPad, La Jolla, CA, USA) using one-way ANOVA. The p-values of less than 0.05 were considered statistically significant. The results were calculated as mean ± SD, and data are shown as mean ±SD.
Results
UV-VIS spectroscopy
Concerning the creation of AgNPs, the color change is an important signal that can be used to track the progress of the reaction. AgNPs of methanolic leaf extract of Pongamia pinnata showed an absorbance peak around 424 nm. (Figure 2c).
DLS
The hydrodynamic diameter of AgNPs was calculated using DLS data. One milliliter of double-distilled water was used to suspend nanoparticles, and measured after being vortexed. At a 173° angle, the scattered light was noticed. Ultrapure water, with a refractive index of 1.33 and a viscosity of 0.89, was used for experimentation at a temperature of 25°C. AgNPs prepared from Pongamia pinnata were found to have an average hydrodynamic diameter of 108±9.5 nm when they were suspended in double-distilled water (Figure 3a).
Zeta Potential
The stability, colloidal characteristics due to electrostatic repulsion, and dispersity all improve with increasing negative or positive potential. The ZETA Potential of Pongamia pinnata was found to be -36.5 mV (Figure 3b).
Figure 3: 3a DLS analysis of AgNPs of Pongamia pinnata with an average hydrodynamic diameter of 108±9.5 nm & 3b shows Zeta Potential results of AgNPs synthesized from methanolic leaf extract of Pongamia pinnata at -36.5 mV.
SEM
Through SEM, the morphology of the green-synthesized AgNPs was analyzed. According to SEM measurements, AgNPs of Pongamia pinnata are between 25 to 50 nm in size. (Figure 4).
Figure 4: Scanning Electron Microscopy (SEM) images of silver nanoparticles (AgNPs) synthesized using Pongamia pinnata leaf extract. The images reveal the morphology and surface characteristics of the biosynthesized nanoparticles. Predominantly spherical nanoparticles are observed, with varying degrees of agglomeration and particle size distribution. The uniformity and surface texture support successful green synthesis using the phytochemicals present in the leaf extract.
Effects of silver nanoparticles on different bacterial strains
The synthesized AgNPs exhibited maximum zone of inhibition against gram-negative E. coli bacterial strain measuring 18.5±0.7mm (100mg/L), 22±1.4mm (200mg/L), and 30.5±0.7mm (300mg/L). This was followed by gram-positive bacterial strain S. aureus measuring 13±1.4mm (100mg/L), 16.5±0.7mm (200mg/L), and 28.5±0.7mm (300mg/L). The least inhibition was observed in P. aeruginosa, measuring 3.5±0.7mm (100mg/L), 6.5±0.7mm (200mg/L), and 11.5±0.7mm (300mg/L) (Figure 5). A graphical representation of all the observed results is shown in Figure 6.
Figure 5: Antibacterial activity of silver nanoparticles (AgNPs) synthesized using Pongamia pinnata leaf extract against Gram-positive and Gram-negative bacteria. The zones of inhibition were measured to assess antibacterial efficacy.
Figure 6: Graphical representation of AgNPs of Pongamia pinnata exhibiting antibacterial activity against gram-positive and gram-negative bacterial strains. With the rise in concentration of AgNPs of Pongamia pinnata zone of inhibition increased significantly.
Discussion
Using Pongamia pinnata, the current study effectively showed the manufacture of AgNPs and assessed their antibacterial activity against clinically relevant bacterial strains. The discussion focuses on the significance of the findings, potential mechanisms underlying the antibacterial activity of AgNPs, comparison with previous studies, limitations, and future directions. The broad-spectrum effectiveness of AgNPs was demonstrated by their antibacterial activity against a variety of gram-positive and gram-negative bacterial strains. This corroborates previous research highlighting the antimicrobial properties of AgNPs, attributed to their ability to induce oxidative stress, disrupt cellular membranes, and interfere with vital cellular processes in bacteria [20]. The potential of AgNPs as substitute antimicrobial agents is highlighted by their apparent antibacterial efficacy, especially when it comes to fighting organisms that are resistant to antibiotics. The exact mechanisms are yet unknown, despite the particles' strong antibacterial action [31]. Nanoscale silver particles have the ability to break down the bacterial membrane, release silver ions constantly, block enzymes, and change the structure of proteins. It is conceivably the mechanism of bacterial death [32]. The utilization of Pongamia pinnata for AgNPs synthesis offers a sustainable and eco-friendly approach, aligning with the growing interest in green synthesis methods to minimize environmental impact. The medicinal plant-based approach not only provides a renewable source of nanoparticles but also harnesses the bioactive compounds present in the plant extract, potentially enhancing the antimicrobial properties of the synthesized AgNPs [33]. Biosynthesized AgNPs were characterized by using UV-VIS spectroscopy for confirmation of synthesis of AgNPs, and an absorbance peak was observed around 424 nm. The formation of small-sized nanoparticles is indicated by the narrow peaks. The existence of silver nanoparticles produced by Pongamia pinnata extracts is indicated by the peaks seen at 424 nm. The reaction mixture's electron surface plasmon resonance caused the peak to rise [39]. Particle size in forms of nanoparticle significantly affects clearance, biodistribution, and circulation half-life. With a particle size of approximately 108.9 nm, the convenience of optimized AgNPs shows that the nanoparticles are within the range and can therefore be absorbed through the skin. This reduced particle size was probably brought about by the ideal pH, temperature, and AgNO3 values. Nonetheless, a significant contribution to the reduction and nucleation mechanism was made by the increased AgNO3 concentration, resulting in AgNPs with reduced particle size properties. The AgNPs' narrow particle size distribution was demonstrated by the optimized formulations' polydispersity index (PDI) value of about 0.227 [40]. The measured zeta values for the produced nanoparticles fell within -36.5 mV, with a zeta deviation of 5.38. By delivering strong negative charges, the capping compound effectively stabilized the nanoparticles, as evidenced by these negative values. The typical threshold for distinguishing between stable and unstable suspensions is set at either +30 mV or -30mV. Generally speaking, particles with zeta potentials more than +30 mV or more negative than 30 mV are regarded as stable, while particles with zeta potentials greater than 15 mV are suspended at the agglomeration threshold [41]. The surface morphology of AgNPs of Pongamia pinnata shows in the range of 25-50 nm.
This study demonstrates the potent antibacterial efficacy of Pongamia pinnata-mediated AgNPs, highlighting their potential as a novel phytomedicine. The biosynthesized AgNPs exhibited significant antibacterial activity against both Gram-positive and Gram-negative bacteria, indicating their broad-spectrum effectiveness. Compared to conventional antibiotics and crude plant extracts, the synthesized nanoparticles showed enhanced bacterial inhibition, likely due to their nano-scale size and synergistic bioactive compounds. Only a portion of the precise mechanism underlying silver ions' antibacterial action is known.
According to a review of the literature, the Ag+ is essential to its antibacterial properties. The electrostatic interaction between the microorganism's negatively charged cell membrane and the positively charged nanoparticles is most likely the source of the antibacterial action [42]. Due to electrostatic attraction and their closer resemblance to sulfur proteins, silver ions can readily cling to the cytoplasmic membrane and cell wall. At the same time, the bacterial envelope is broken apart because silver ions that adhere to the cytoplasmic membrane or cell wall increase the cell's permeability, which in turn causes cell breakdown. Free silver ions block respiratory enzymes when they are absorbed by cells, producing reactive oxygen species that stop the synthesis of adenosine triphosphate [43]. The primary component that triggers DNA alteration and cell membrane rupture is reactive oxygen species(ROS). Sulfur and phosphate are necessary building blocks of DNA. Nevertheless, AgNPs' interaction with sulfur and phosphorus in DNA can hinder DNA replication, interfere with cell division, or even kill bacteria. Because silver ions can prevent protein production, the ribosome may occasionally become denaturated in the cytoplasm [44].
These findings underscore the promise of Pongamia pinnata-derived AgNPs as a sustainable and eco-friendly alternative for combating bacterial infections. Further studies on toxicity, stability, and clinical applications will be crucial to advancing their role in biomedical and pharmaceutical fields.
Conclusion
In this study, we successfully demonstrated the eco-friendly synthesis of (AgNPs) using Pongamia pinnata leaf extract, highlighting a sustainable and green alternative to conventional chemical methods. The biosynthesized AgNPs exhibited significant antibacterial activity against a range of pathogenic bacteria, underscoring their potential as a novel therapeutic agent. The use of Pongamia pinnata, a readily available medicinal plant, not only contributes to environmentally benign nanoparticle fabrication but also adds synergistic bioactivity due to its inherent phytochemicals. These findings suggest that plant-mediated AgNPs can serve as effective, low-cost, and biocompatible antimicrobial agents, paving the way for future applications in medical and pharmaceutical fields. Further research is warranted to investigate their in vivo efficacy, toxicity profile, and mechanism of action, thereby fully establishing their therapeutic potential.
Declarations
Acknowledgments
The authors recognize the facilities provided for experimental work by the Head of the Department of Zoology at the University of Rajasthan in Jaipur, India, & P.I. Project number 5 RUSA2.O.
Author contributions
P.Y. Conceptualization, Investigation, Data curation, Writing—original draft, review & editing, Data curation, Formal analysis, Methodology; N.B. Conceptualization, and Writing—review & editing, Investigation, Methodology; P.C.M. Methodology, supervision, Project administration, Validation.
Funding
In addition to the Council of Scientific and Industrial Research (CSIR), New Delhi, for financial support, Authors are thankful, in the form of SRF (09/0149(13697)/2022-EMR-I).
Data availability
The authors declare that the data supporting the findings in this study are presented within the paper. The data presented in this article are also available upon request from the corresponding author.
Statements and Declarations
Conflict of interest
The authors declare that they have no conflict of interest.
Consent to participate
Not applicable.
References
- Asif, M., Yasmin, R., Asif, R., Ambreen, A., Mustafa, M., & Umbreen, S. (2022). Green synthesis of silver nanoparticles (AgNPs): structural characterization, and their antibacterial potential. Dose Response, 20(1):1–11.
Publisher | Google Scholor - Wahab, M., & Janaswamy, S. (2023). A review on biogenic silver nanoparticles as efficient and effective antidiabetic agents. Functional Food Science, 3(7):93–97.
Publisher | Google Scholor - Iravani, S. (2011). Green synthesis of metal nanoparticles using plants. Green Chemistry, 13(10):2638–2650.
Publisher | Google Scholor - Zubair, M., Azeem, M., Mumtaz, R., Younas, M., Adrees, M., Zubair, E., Khalid, A., Hafeez, F., Rizwan, M., & Ali, S. (2022). Green synthesis and characterization of silver nanoparticles from Acacia nilotica and their anticancer, antidiabetic and antioxidant efficacy. Environmental Pollution, 304:119249.
Publisher | Google Scholor - Jannathul Firdhouse, M., & Lalitha, P. (2015). Biosynthesis of silver nanoparticles and its applications. Journal of Nanotechnology, 2015:1–18.
Publisher | Google Scholor - Goyal, S., Gupta, N., Kumar, A., Chatterjee, S., & Nimesh, S. (2018). Antibacterial, anticancer and antioxidant potential of silver nanoparticles engineered using Trigonella foenum-graecum seed extract. IET Nanobiotechnology, 12:526–533.
Publisher | Google Scholor - Poulose, S., Panda, T., Nair, P. P., & Théodore, T. (2014). Biosynthesis of silver nanoparticles. Journal of Nanoscience and Nanotechnology, 14(2):2038–2049.
Publisher | Google Scholor - Yadav, P., Bharti, N., Sharma, P. K., & Mali, P. C. (2025). Cassia auriculata-derived silver nanoparticles as a novel male contraceptive agent. Pharmacological Research-Modern Chinese Medicine, 15:100626.
Publisher | Google Scholor - Shiraishi, Y., & Toshima, N. (2000). Oxidation of ethylene catalyzed by colloidal dispersions of poly(sodium acrylate)-protected silver nanoclusters. Colloids and Surfaces A: Physicochemical and Engineering Aspects, 169:59–66.
Publisher | Google Scholor - Zamiri, R., Azmi, B. Z., Sadrolhosseini, A. R., Ahangar, H. A., Zaidan, A. W., & Mahdi, M. A. (2011). Preparation of silver nanoparticles in virgin coconut oil using laser ablation. International Journal of Nanomedicine, 6:71–75.
Publisher | Google Scholor - Rao, B., & Tang, R. C. (2017). Green synthesis of silver nanoparticles with antibacterial activities using aqueous Eriobotrya japonica leaf extract. Advances in Natural Sciences: Nanoscience and Nanotechnology, 8(1):5014.
Publisher | Google Scholor - Khandel, P., Shahi, S. K., Soni, D. K., Yadaw, R. K., & Kanwar, L. (2018). Alpinia calcarata: A potential source for the fabrication of bioactive silver nanoparticles. Nano Convergence, 5(1):37.
Publisher | Google Scholor - Rengarajan, S., Sivalingam, A. M., Pandian, A., & Chaurasia, P. K. (2024). Nanomaterial (AgNPs) synthesis using Calotropis gigantea extract, characterization, and biological application in antioxidant and antibacterial activity. Journal of Inorganic and Organometallic Polymers and Materials, 34:4005–4020.
Publisher | Google Scholor - Udayasoorian, C., Kumar, K., & Jayabalakrishnan, R. M. (2011). Extracellular synthesis of silver nanoparticles using leaf extract of Cassia auriculata. Digest Journal of Nanomaterials and Biostructures, 6.
Publisher | Google Scholor - Yadav, P., Bharti, N., Kanstiya, A. K., & Mali, P. C. (2024). Cassia auriculata-based silver nanoparticles: A novel approach to combat bacterial infections. SSR Institute International Journal of Life Sciences, 10(6):6360–6370.
Publisher | Google Scholor - Mali, P. C., Bharti, N., Yadav, P., & Kansotiya, A. K. (2024). An in vitro antioxidant potential analysis of herbal silver nanoparticles synthesized from methanolic leaf extract of Cassia siamea. IP International Journal of Comprehensive and Advanced Pharmacology, 9(4):275–283.
Publisher | Google Scholor - Yadav, P., Bharti, N., Kansotiya, A. K., Kumari, S., Yadav, R. K., & Mali, P. C. (2023). Potential antifertility and antimicrobial activities of plants used in traditional medicines: A review. Journal of Pharmacognosy and Phytochemistry, 12(2):190–198.
Publisher | Google Scholor - Bala, M., Nag, T. N., Kumar, S., Vyas, M., Kumar, A., & Bhogal, N. S. (2011). Proximate composition and fatty acid profile of Pongamia pinnata, a potential biodiesel crop. Journal of the American Oil Chemists' Society, 88:559–562.
Publisher | Google Scholor - Shameel, S., Usmanghani, K., Ali, M. S., & Ahmad, V. U. (1996). Chemical constituents from the seeds of Pongamia pinnata (L.) Pierre. Pakistan Journal of Pharmaceutical Sciences, 9(1):11–20.
Publisher | Google Scholor - Paul, M., & Londhe, V. Y. (2018). Pongamia pinnata seed extract-mediated green synthesis of silver nanoparticles: Preparation, formulation and evaluation of bactericidal and wound healing potential. Applied Organometallic Chemistry, e4624.
Publisher | Google Scholor - Yadav, P., & Mali, P. C. (2024). Testicular inflammation in male reproductive system. Exploration of Immunology, 4(4):446–464.
Publisher | Google Scholor - Sattar, A., Raza, S., Sarfraz, S., Shahzad, M., Farooq, M., & Shabbir, A. (2024). Phytochemical analysis and antimicrobial activity of Pongamia pinnata: A comprehensive study. Journal of Health and Rehabilitation Research, 4:196–202.
Publisher | Google Scholor - Ansari, M. A., & Alzohairy, M. A. (2018). One-pot facile green synthesis of silver nanoparticles using seed extract of Phoenix dactylifera and their bactericidal potential against MRSA. Evidence-Based Complementary and Alternative Medicine, 2018:1–9.
Publisher | Google Scholor - Khan, S., & Mali, P. C. (2017). Reversible antifertility effect of Cassia tora Linn in male rats. International Journal of Life Sciences Scientific Research, 3(5):1415–1423.
Publisher | Google Scholor - Arora, D. S., & Kaur, G. J. (2007). Antibacterial activity of some Indian medicinal plants. Journal of Natural Medicines, 61:313–317.
Publisher | Google Scholor - Baral, S. R., & Kurmi, P. P. (2006). Compendium of medicinal plants in Nepal, 457–462. Rachana Sharma.
Publisher | Google Scholor - Akram, M., Nimesh, S., Chishti, M. A., Ahmad, M. I., Dhama, S., & Lal, M. (2021). Pongamia pinnata: An updated review on its phytochemistry and pharmacological uses. Pharmacology & Pharmacokinetics International Journal, 9(5):194–199.
Publisher | Google Scholor - Kuppusamy, P., Ichwan, S. J. A., Parine, N. R., Yusoff, M. M., Maniam, G. P., & Govindan, N. (2015). Intracellular biosynthesis of Au and Ag nanoparticles using ethanolic extract of Brassica oleracea L. and studies on their physiochemical and biological properties. Journal of Environmental Sciences, 29:151–157.
Publisher | Google Scholor - Sanjida Akhter, M., Rahman, M. A., Ripon, R. K., Mubarak, M., Akter, M., Mahbub, S., Mamun, F. A., & Sikder, M. T. (2024). A systematic review on green synthesis of silver nanoparticles using plant extract and their biomedical applications. Heliyon, 10(11):e29766.
Publisher | Google Scholor - Ajay, E., & Afolayan, A. (2017). Green synthesis, characterization and biological activities of silver nanoparticles from alkalinized Cymbopogon citratus Stapf. Advances in Natural Sciences: Nanoscience and Nanotechnology, 8.
Publisher | Google Scholor - Beg, M., Maji, A., Mandal, A. K., Das, S., Aktara, M. N., Jha, P. K., & Hossain, M. (2017). Green synthesis of silver nanoparticles using Pongamia pinnata seed: Characterization, antibacterial property, and spectroscopic investigation of interaction with human serum albumin. Journal of Molecular Recognition, 30(1):e2565.
Publisher | Google Scholor - Lasmi, F., Hamitouche, H., Laribi-Habchi, H., Benguerba, Y., & Chafai, N. (2025). Silver nanoparticles (AgNPs):methods of synthesis, characterization, and their application: A review. Plasmonics.
Publisher | Google Scholor - Rajeshkumar, S. (2016). Synthesis of silver nanoparticles using fresh bark of Pongamia pinnata and characterization of its antibacterial activity against gram-positive and gram-negative pathogens. Resource-Efficient Technologies, 2(1):30–35.
Publisher | Google Scholor - Bawazeer, S. (2025). Green synthesis: An eco-friendly approach for the synthesis of silver nanoparticles functionalized with Operculina turpethum and its in vitro and in vivo biological activities. International Journal of Nanomedicine, 20:2991–3005.
Publisher | Google Scholor - Poudel, D. K., Niraula, P., Aryal, H., Budhathoki, B., Phuyal, S., Marahatha, R., & Subedi, K. (2021). Plant-mediated green synthesis of AgNPs and their possible applications: A critical review. Journal of Nanotechnology, 2022(1):2779237.
Publisher | Google Scholor - Sharma, N. K., Vishwakarma, J., Rai, S., Alomar, T. S., Almasoud, N., & Bhattarai, A. (2022). Green route synthesis and characterization techniques of silver nanoparticles and their biological adeptness. ACS Omega, 7(31):27004–27020.
Publisher | Google Scholor - Cervantes, B., Arana, L., Murillo-Cuesta, S., Bruno, M., Alkorta, I., & Varela-Nieto, I. (2019). Solid lipid nanoparticles loaded with glucocorticoids protect auditory cells from cisplatin-induced ototoxicity. Journal of Clinical Medicine, 8(9):1464.
Publisher | Google Scholor - Dubey, S. P., Lahtinen, M., & Sillanpää, M. (2010). Green synthesis and characterization of silver and gold nanoparticles using leaf extract of Rosa rugosa. Colloids and Surfaces A: Physicochemical and Engineering Aspects, 364:34–41.
Publisher | Google Scholor - Naik, B. R., Gowreeswari, G. S., Singh, Y., Satyavathi, R., Daravath, S. S., & Reddy, P. R. (2014). Bio-synthesis of silver nanoparticles from leaf extract of Pongamia pinnata as an effective larvicide on dengue vector Aedes albopictus (Skuse) (Diptera: Culicidae). Advances in Entomology, 2(2):93–101.
Publisher | Google Scholor - Telange, D. R., Mahajan, N. M., Mandale, T., More, S., & Warokar, A. (2024). Pongamia pinnata seed extract-mediated green synthesis of silver nanoparticle loaded nanogel for estimation of their antipsoriatic properties. Bioprocess and Biosystems Engineering, 47(8):1409–1431.
Publisher | Google Scholor - Priya, R. S., Geetha, D., & Ramesh, P. S. (2016). Antioxidant activity of chemically synthesized AgNPs and biosynthesized Pongamia pinnata leaf extract-mediated AgNPs – A comparative study. Ecotoxicology and Environmental Safety, 134:308–318.
Publisher | Google Scholor - Raut, R. W., Kolekar, N. S., Lakkakula, J. R., Mendhulkar, V. D., & Kashid, S. B. (2010). Extracellular synthesis of silver nanoparticles using dried leaves of Pongamia pinnata (L.) Pierre. Nano-Micro Letters, 2(2):106–113.
Publisher | Google Scholor - Jin, J., Wu, Y., Liang, L., Wei, Y., Zheng, X., & Chen, Y. (2023). Altering silver nanoparticles-induced inhibition to bacterial denitrification via visible light by regulating silver transformation and adaptive mechanism under anaerobic conditions. Chemical Engineering Journal, 452:139268.
Publisher | Google Scholor - More, P. R., Pandit, S., Filippis, A., Franci, G., Mijakovic, I., & Galdiero, M. (2023). Silver nanoparticles: Bactericidal and mechanistic approach against drug-resistant pathogens. Microorganisms, 11(2):369.
Publisher | Google Scholor - Linz, M. S., Mattappallil, A., Finkel, D., & Parker, D. (2023). Clinical impact of Staphylococcus aureus skin and soft tissue infections. Antibiotics, 12(3):1–27.
Publisher | Google Scholor - Bashabsheh, R. H. F., AL-Fawares, O., Natsheh, I., Bdeir, R., Al-Khreshieh, R. O., & Bashabsheh, H. H. F. (2024). Staphylococcus aureus epidemiology, pathophysiology, clinical manifestations and application of nano-therapeutics as a promising approach to combat methicillin-resistant Staphylococcus aureus. Pathogens and Global Health, 118(3):209–231.
Publisher | Google Scholor - McDowell, R. H., Sands, E. M., & Friedman, H. (2023). Bacillus cereus. In StatPearls. StatPearls Publishing.
Publisher | Google Scholor - Mueller, M., & Tainter, C. R. (2023). Escherichia coli infection. In StatPearls. StatPearls Publishing.
Publisher | Google Scholor - Wilson, M. G., & Pandey, S. (2023). Pseudomonas aeruginosa. In StatPearls. StatPearls Publishing.
Publisher | Google Scholor